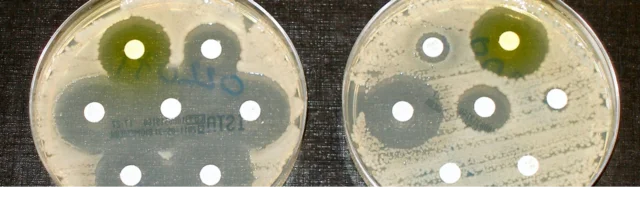
La teoría microbiana

-
 Desde la Antigüedad
Desde la Antigüedad
Se creía que las enfermedades eran causadas por la magia o la hechicería (Volcy, 2007).
En las primeras culturas, la enfermedad se entendía como la intrusión de cuerpos extraños o espíritus malvados que debían ser liberados del paciente (Volcy, 2007). -
 La Teoría Humoral
La Teoría Humoral
Periodo: Más de 2000 años, desde la antigua Grecia.
La teoría, liderada por Hipócrates y Galeno, se basa en la idea de que la salud y la enfermedad dependen del equilibrio de los humores corporales, una noción que se extendió a la fitopatología (Volcy, 2007). -
 Murieron millones de personas. Asociados a acontecimientos anormales, como sequías, terremotos o la aparición de cometas, vistos como presagios de la enfermedad (Volcy, 2007). La bacteria Yersinia pestis es transmitida por pulgas infectadas procedentes de roedores. Se tiene constancia de que hace unos 4.300 años en el noreste asiático, este padecimiento ya afectó al ser humano (Universidad de Valladolid, 2025).
Murieron millones de personas. Asociados a acontecimientos anormales, como sequías, terremotos o la aparición de cometas, vistos como presagios de la enfermedad (Volcy, 2007). La bacteria Yersinia pestis es transmitida por pulgas infectadas procedentes de roedores. Se tiene constancia de que hace unos 4.300 años en el noreste asiático, este padecimiento ya afectó al ser humano (Universidad de Valladolid, 2025). -
 En la antigua India, la literatura Veda (1500-500 a.C.) contenía conjuros para alejar las enfermedades de las plantas, mientras que los babilonios y sumerios rendían culto a la diosa Ninkilim para proteger sus cultivos (Volcy, 2007).
En la antigua India, la literatura Veda (1500-500 a.C.) contenía conjuros para alejar las enfermedades de las plantas, mientras que los babilonios y sumerios rendían culto a la diosa Ninkilim para proteger sus cultivos (Volcy, 2007). -
 Periodo. Desde el año 2000 a.C.
Periodo. Desde el año 2000 a.C.
o La enfermedad era vista como un castigo divino por haber cometido un crimen o haber sido negligente, una visión que se manifestaba en la pandemia de la peste negra (Volcy, 2007). -
 año: 2000 a.c. En la agricultura, las primeras enfermedades infecciosas de plantas fueron registradas en Mesopotamia alrededor del 2000 a.C. (Volcy, 2007). Las enfermedades que se presentan en las plantas se pueden clasificar como alteraciones fisiológicas y morfológicas, las cuales son producidas por agentes bióticos o abióticos respectivamente. Las primeras son causadas por hongos, virus y bacterias (Hidroponía, 2017).
año: 2000 a.c. En la agricultura, las primeras enfermedades infecciosas de plantas fueron registradas en Mesopotamia alrededor del 2000 a.C. (Volcy, 2007). Las enfermedades que se presentan en las plantas se pueden clasificar como alteraciones fisiológicas y morfológicas, las cuales son producidas por agentes bióticos o abióticos respectivamente. Las primeras son causadas por hongos, virus y bacterias (Hidroponía, 2017). -
 Anunciada cuatro años antes
Anunciada cuatro años antes
por la aparición de cometas, la erupción del volcán
Vesubio, la caída de una lluvia roja y terremotos
continuos (Volcy, 2007). evento histórico en el que un brote de gripe se originó en Europa, siendo el primer brote indiscutible registrado en este continente y que le dio su nombre al virus debido a la creencia de que las estrellas influían en la enfermedad. -
 Se postuló entre 1693 y 1742, también se basó en el concepto humoral, sugiriendo que las enfermedades eran causadas por la alteración de la consistencia de las partes sólidas del cuerpo (Volcy, 2007). Hoffmann no se basó en el concepto de elementos como la Madera, Fuego, Tierra, Metal y Agua, ni en sistemas de la medicina china. Su teoría se enfocaba en una interacción más directa entre los componentes físicos del cuerpo.
Se postuló entre 1693 y 1742, también se basó en el concepto humoral, sugiriendo que las enfermedades eran causadas por la alteración de la consistencia de las partes sólidas del cuerpo (Volcy, 2007). Hoffmann no se basó en el concepto de elementos como la Madera, Fuego, Tierra, Metal y Agua, ni en sistemas de la medicina china. Su teoría se enfocaba en una interacción más directa entre los componentes físicos del cuerpo. -
Periodo: Desde la Antigüedad hasta el Siglo XIX
Los antiguos papiros egipcios ya clasificaban las enfermedades como internas o externas. Esta noción se mantuvo en la fitopatología, ya que en 1705 el francés Joseph Pitton de Tournefort clasificó las enfermedades de las plantas de esta manera (Volcy, 2007). -
La teoría microbiana sin Pasteur y Koch
Periodo: Siglo XVI
El médico medieval Girolamo Fracastoro se refería a las "semillas" de la sífilis, mientras que otros pensadores, como Thomas Sydenham y Richard Morton, usaron los términos "partículas morbíficas" y la "teoría animalcular" de la enfermedad, sentando las bases de una visión más allá de las nociones supersticiosas (Volcy, 2007). -
El francés Duhamel du Monceau publicó un documento sobre la enfermedad de la azafrán, describiendo cómo el hongo causaba la enfermedad al ser inoculado en plantas sanas. Con esto, logró la primera prueba experimental de patogenicidad, un hito antes de los trabajos de Pasteur y Koch (Volcy, 2007).
-
 Periodo: Dominó hasta el siglo XIX.
Periodo: Dominó hasta el siglo XIX.
o Esta teoría atribuía las enfermedades a los miasmas, o "mal aire", exhalaciones pútridas y vapores que emanaban de la materia orgánica en descomposición (Volcy, 2007).
o Se creía que la inhalación de estos vapores causaba enfermedades como la malaria y el cólera, y que la insalubridad de las ciudades, con sus malos olores, era la principal causa de las epidemias (Volcy, 2007). -
 Fueron muchos los irlandeses que decidieron emigrar en vez de pasar hambre, aunque éstos también pusieron en gran riesgo sus vidas. En los conocidos como "barcos ataúdes", los traficantes de la época embarcaban a la mayor cantidad de pasajeros posible para realizar la travesía del Atlántico, proveyéndoles de la mínima cantidad de agua y comida (Sadurní, 2020).
Fueron muchos los irlandeses que decidieron emigrar en vez de pasar hambre, aunque éstos también pusieron en gran riesgo sus vidas. En los conocidos como "barcos ataúdes", los traficantes de la época embarcaban a la mayor cantidad de pasajeros posible para realizar la travesía del Atlántico, proveyéndoles de la mínima cantidad de agua y comida (Sadurní, 2020). -
Apodada "el cólera de la papa", fue atribuida a la contaminación del aire por el humo de las locomotoras o a la electricidad atmosférica, demostrando la vigencia de la teoría miasmática en la agricultura (Volcy, 2007).
-
En fitopatología, se sugería que los vapores nocivos provenientes de ríos y pantanos podían causar enfermedades en las plantas y reducir su rendimiento, como se describe en el documento bizantino Geoponica (Volcy, 2007).
-
Periodo: 1807
El suizo Isaac-Bénédict Prévost demostró que las esporas de un hongo eran la causa de la caries del trigo al observar que, cuando se inoculaban en plantas sanas, estas desarrollaban la enfermedad. Esto fue una evidencia temprana de la relación causal entre un patógeno y una enfermedad (Volcy, 2007). -
Periodo: Desde la Antigüedad hasta el Siglo XIX
Esta teoría proponía que las estrellas y los planetas influenciaban la salud, causando enfermedades. En el Medioevo, se creía que la conjunción de Saturno, Júpiter y Marte causó la peste negra (Volcy, 2007). -
 Se relacionó con las fases de la luna y la aparición del cometa Halley en 1835 (Volcy, 2007). La epidemia de cólera que azotó Europa durante el siglo XIX tuvo su origen en 1817 a orillas del Ganges, en la India y varios paises más (de Mattei, 2020).
Se relacionó con las fases de la luna y la aparición del cometa Halley en 1835 (Volcy, 2007). La epidemia de cólera que azotó Europa durante el siglo XIX tuvo su origen en 1817 a orillas del Ganges, en la India y varios paises más (de Mattei, 2020). -
 la enfermedad
la enfermedad
fungosa "roya de la cebada", por ejemplo,
encontraba su razón de ser en los astros, bien
porque su gravedad coincidía con la luna llena. causada por hongos del género Puccinia, y su naturaleza se conocía desde la antigüedad, con registros históricos que la incluyen entre las afecciones de plantas. -
• Periodo: 1845-1868
La "gota de la papa" que causó la hambruna en Irlanda de 1845-1852 sirvió como base para el estudio de enfermedades en plantas. En 1866, el alemán Antón De Bary confirmó que un hongo era el agente causal, reproduciendo la enfermedad en plantas sanas (Volcy, 2007).
Además, en este periodo se aplicaron versiones incompletas de los postulados de Koch a los primeros estudios de enfermedades bacterianas en plantas (Volcy, 2007). -
Periodo: Mediados del siglo XIX
Periodo: Mediados del siglo XIX
Esta teoría, que revolucionó la medicina y la fitopatología, fue consolidada por los trabajos de Louis Pasteur y Robert Koch, quienes demostraron que las enfermedades son causadas por microorganismos (Volcy, 2007). -
En 1857, Pasteur publicó sus primeros estudios sobre la fermentación y en 1865 identificó una estructura corpuscular en los gusanos de seda, lo que lo llevó a establecer la noción de una causa necesaria para la enfermedad (Volcy, 2007).
-
Hipócrates fue uno de los primeros en proponer una clasificación de las enfermedades según los síntomas, dividiéndolas en categorías como enfermedades de la cabeza, piel o la cavidad corporal (Volcy, 2007).
En 1862, el profesor Augustin Grisolle en París clasificó las enfermedades según su causa, utilizando términos como "venenos sépticos" y "secreciones mórbidas" (Volcy, 2007). -
Robert Koch, por su parte, investigó la etiología del ántrax en 1876 y luego, entre 1877 y 1878, estudió las infecciones en heridas, estableciendo el concepto de causa suficiente (Volcy, 2007).
-
En 1882, Koch formuló sus postulados, un marco experimental que define la relación causa-efecto entre un microorganismo y una enfermedad, estableciendo que el patógeno debe estar presente en el hospedero enfermo y ausente en el sano (Volcy, 2007).
-
Hacia 1892, Charles Bouchard, en su texto "Los microbios patógenos", las clasificó como específicas, no específicas o parasíticas, sentando una base para la taxonomía moderna de las enfermedades (Volcy, 2007).
-
Además de las teorías principales, existieron otras formas de clasificar las causas de las enfermedades. Hipócrates ya había sugerido que la salud estaba influenciada por el clima, lo que creaba un balance de humores (Volcy, 2007).
El médico cubano Carlos Finlay propuso que la fiebre amarilla era el resultado de la interacción de tres causas: individuales (edad, sexo), atmosféricas (humedad, calor) y telúricas (condiciones del suelo) (Volcy, 2007). -
En la fitopatología, George W. Keitt y Harshberger clasificaron las causas de las enfermedades de las plantas en categorías como causa directa o inmediata y causa secundaria (condiciones ambientales). Harshberger también incluyó las causas predisponentes (la constitución del hospedero) y las causas determinativas (agentes animados o enzimas) (Volcy, 2007).
A list shows items. A timeline shows sequence.
Use Timetoast to make dates, milestones, and turning points easier to understand in a clear visual format. Timetoast is a timeline maker for work, school, research, and stories.